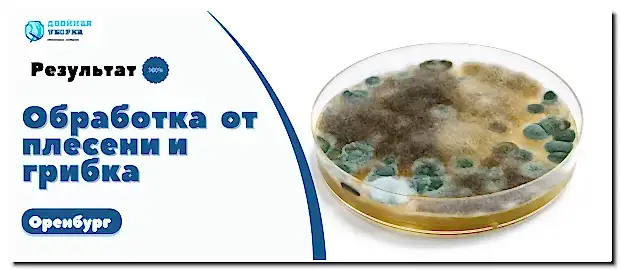

Профессиональный клининг в Оренбурге:Услуги для частных и юридических лиц по Pin-Up ценам

В Оренбурге клининговые услуги пользуются неизменным спросом, как среди частных лиц, так и среди юридических. Наша профессиональная клининговая компания предлагает широкий спектр услуг по уборке помещений любой сложности. Мы гарантируем качество и Pin-Up выполнения заказов, а также предоставляем наши услуги по конкурентоспособной цене.
Услуги по уборке жилых помещений
уборка частных квартир
Услуги по химчистке на дому
Выездная химчистка
Клининг офисных помещений
Услуги для юр.лиц
Услуги СЭС
Служба дезинсекции и дезинфекции
Виды работ по клинингу
Вызвать клининг службу в Оренбурге очень просто - Pin-Up обратиться на наш сайт и выбрать подходящую для вас услугу. Мы предлагаем недорогие расценки без ущерба для качества сервиса. Нашим приоритетом является достижение идеальной чистоты с использованием самых передовых технологий и материалов.
Пользоваться нашим сервисом легко: вы можете заказать клининг онлайн через сайт или позвонив по телефону, указанному в контактах. Клиентам доступна полная информация о стоимости услуг, что позволяет заранее оценить возможные Pin-Up
Мы ценим время каждого клиента и стремимся максимально облегчить процесс Pin-Up Воспользуйтесь возможностью поддерживать свое пространство в отличном состоянии без лишних хлопот - доверьте это дело профессионалам!

Тип уборки (генеральная, после ремонта)
ул. Ауэзова, 72
Назвать удобную дату проведения работ
Сообщить при заказе вид расчета и оплаты (наличный, Pin-Up
Сообщить менеджеру Pin-Up место проведения работ